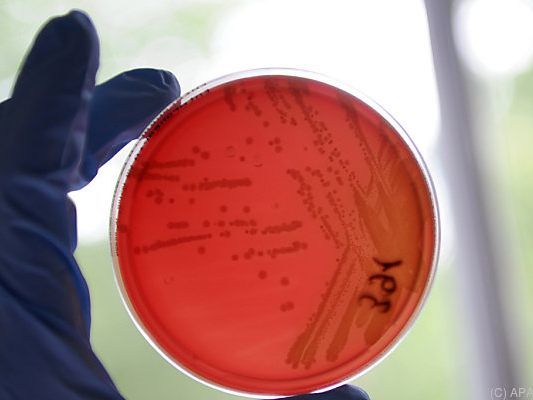

Steigende Zahl von Ehec-Infektionen in USA - Fünf Tote
Insgesamt seien mittlerweile 35 Bundesstaaten vom Ausbruch betroffen, wie die US-Gesundheitsbehörde CDC in Atlanta am Freitag (Ortszeit) mitteilte. Todesfälle verzeichneten die Bundesstaaten Kalifornien, Arkansas, Minnesota und New York, hieß es.
Anfang Mai hatte die CDC zunächst einen Toten und insgesamt rund 120 Infizierte gemeldet. Offenbar stammt der Erreger aus einem Typ Römersalat aus der Region Yuma, die im südlichen Bundesstaat Arizona an der Grenze zu Mexiko liegt. Die ersten Krankheitsfälle wurden laut CDC Mitte März gemeldet. Die Behörde hatte zunächst dazu aufgerufen, keinen Römersalat aus der Gegend zu essen. Später wurde die Warnung aber wieder aufhoben, da das Gemüse in Yuma seit Mitte April nicht mehr geerntet wird. Einige Betroffene hatten aber offenbar selbst keinen Salat gegessen, sondern lediglich engeren Kontakt mit Infizierten.
Kann zu Nierenversagen führen
Der Ehec-Erreger kann blutige Durchfälle auslösen und in schweren Fällen zu Nierenversagen führen, es gibt aber auch unscheinbare Verläufe. In den USA seien 89 Menschen wegen der Infektion ins Krankenhaus gekommen, 26 davon litten an Nierenversagen, teilte die CDC mit.
Ehec ist ein oft sehr ansteckender, aggressiver Erreger und eine Sonderform der Kolibakterien. Der schwere Verlauf einer Erkrankung endet in etwa zwei Prozent der Fälle tödlich. 2011 verursachte Ehec in Österreich und Deutschland eine Lebensmittelkrise. Vor allem in Norddeutschland grassierte eine schwere Infektionswelle, Hunderte Menschen erkrankten teils schwer, Dutzende starben.
(APA/dpa)





